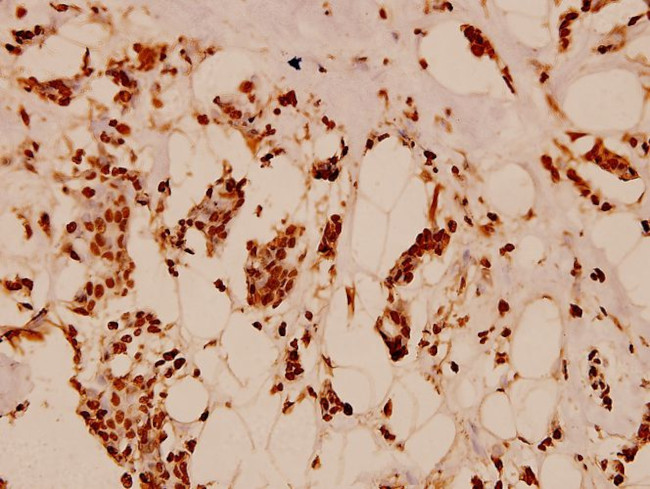
Histone H2B Antibody in Immunohistochemistry (Paraffin) (IHC (P))

Search
Invitrogen
Histone H2B Polyclonal Antibody
{{$productOrderCtrl.translations['antibody.pdp.commerceCard.promotion.promotions']}}
{{$productOrderCtrl.translations['antibody.pdp.commerceCard.promotion.viewpromo']}}
{{$productOrderCtrl.translations['antibody.pdp.commerceCard.promotion.promocode']}}: {{promo.promoCode}} {{promo.promoTitle}} {{promo.promoDescription}}. {{$productOrderCtrl.translations['antibody.pdp.commerceCard.promotion.learnmore']}}

Please note: We are reviewing Western blot images included in the antibody testing data in our catalog, including those provided by third parties. Unless expressly labeled or annotated as “raw-unedited”, Western blot images included in the antibody testing data in our catalog may have been edited, optimized or otherwise adjusted for presentation.
产品信息
PA5-86321
种属反应
宿主/亚型
分类
类型
抗原
偶联物
形式
浓度
规格
纯化类型
保存液
内含物
保存条件
运输条件
RRID
产品详细信息
Purity is > 95% by SDS-PAGE.
靶标信息
Histones are basic nuclear proteins that are responsible for the nucleosome structure of the chromosomal fiber in eukaryotes. Nucleosomes consist of approximately 146 bp of DNA wrapped around a histone octamer composed of pairs of each of the four core histones (H2A, H2B, H3, and H4). The nucleosomes wrap further and compact DNA into chromotin, limiting DNA accessibility to the cellular machineries which require DNA as a template. Histones play a central role in transciption regulation, DNA repair, DNA replication, and chromosomal stability. H2B has a broad antibacterial activity.
仅用于科研。不用于诊断过程。未经明确授权不得转售。
篇参考文献 (0)
生物信息学
蛋白别名: Acetyl-Histone H2; H2B 291A; H2B 291B; H2b 613; H2B GL105 antibody; H2B histone family member W testis-specific; H2B histone family, member S; H2B K; H2B type 12; h2B-143; h2B-221; H2B-clustered histone 17; H2B-clustered histone 18; H2B-clustered histone 21; H2B-clustered histone 26; H2B-clustered histone 3; H2B-clustered histone 5; H2B-clustered histone 9; H2B.1 antibody; H2B.U histone 1; H2B.W histone 1; H2B/a; H2B/b; H2B/c; H2B/d; H2B/e; H2B/f; H2B/g; H2B/h; H2B/I; H2B/j; H2B/k; H2B/l; H2B/n; H2B/q; H2B/r; H2B/s; H2BK12ac; H2BK15ac; H2BK5ac; H2BS14; H2BS14p; HIRA-interacting protein 1; HIRA-interacting protein 2; HIST1H2BB antibody; HIST1H3I; histone 1, H2ba; histone 1, H2bb; histone 1, H2bc; histone 1, H2bg; histone 1, H2bh; histone 1, H2bj; histone 1, H2bk; histone 1, H2bm; histone 2, H2be; Histone 2B; Histone H2B type 1-A; Histone H2B type 1-B; Histone H2B type 1-C/E/F/G/I; Histone H2B type 1-C/E/G; Histone H2B type 1-D; Histone H2B type 1-F/J/L; Histone H2B type 1-H; Histone H2B type 1-J; Histone H2B type 1-K; Histone H2B type 1-L; Histone H2B type 1-M; Histone H2B type 1-N; Histone H2B type 1-O; Histone H2B type 2-E; Histone H2B type 2-E1; Histone H2B type 2-F; Histone H2B type 2-K1; Histone H2B type 3-B; Histone H2B type F-M; Histone H2B type W-T; Histone H2B, testis; Histone H2B-GL105; Histone H2B.1; Histone H2B.1 A; Histone H2B.1 B; Histone H2B.2; Histone H2B.a; Histone H2B.b; Histone H2B.c; Histone H2B.d; Histone H2B.e; Histone H2B.f; Histone H2B.g; Histone H2B.h; Histone H2B.I; Histone H2B.j; Histone H2B.k; Histone H2B.l; Histone H2B.n; Histone H2B.q; Histone H2B.r; Histone H2B.s; MGC125414; MGC125415; MGC125416; MGC9388; RP1-193B12.10; Testis-specific histone H2B; TSH2B.1
基因别名: 2610022J01Rik; AV127319; H2b-143; H2b-221; H2b-291b; H2b-613; H2b-f; H2b-j; H2b-l; H2b-n; H2BC1; H2BC10; H2BC11; H2BC12; H2BC13; H2BC14; H2BC15; H2BC17; H2BC18; H2BC21; H2BC26; H2BC3; H2BC4; H2BC5; H2BC6; H2BC7; H2BC8; H2BC9; H2BE1; H2BFA; H2BFB; H2BFC; H2BFD; H2BFE; H2BFF; H2BFG; H2BFH; H2BFJ; H2BFK; H2BFL; H2BFM; H2BFN; H2BFQ; H2BFR; H2bfs; H2BFT; H2BFWT; H2BK1; H2BU1; H2BW1; H2BW2; HIRIP1; HIRIP2; HIST1H2BA; HIST1H2BB; HIST1H2BC; HIST1H2BD; HIST1H2BE; HIST1H2BF; HIST1H2BG; HIST1H2BH; HIST1H2BI; HIST1H2BJ; HIST1H2BK; HIST1H2BL; HIST1H2BM; HIST1H2BN; HIST1H2BO; HIST2H2BE; HIST2H2BF; HIST3H2BB; R74621; T25626; Th2b; TH2B-175; TSH2B
UniProt ID: (Mouse) P70696, (Mouse) Q64475, (Mouse) Q6ZWY9, (Mouse) Q64478, (Mouse) P10853, (Mouse) Q8CGP1, (Mouse) P10854, (Mouse) Q64524
Entrez Gene ID: (Mouse) 319177, (Mouse) 319178, (Mouse) 68024, (Mouse) 319181, (Mouse) 319182, (Mouse) 319183, (Mouse) 319184, (Mouse) 319186, (Mouse) 319190